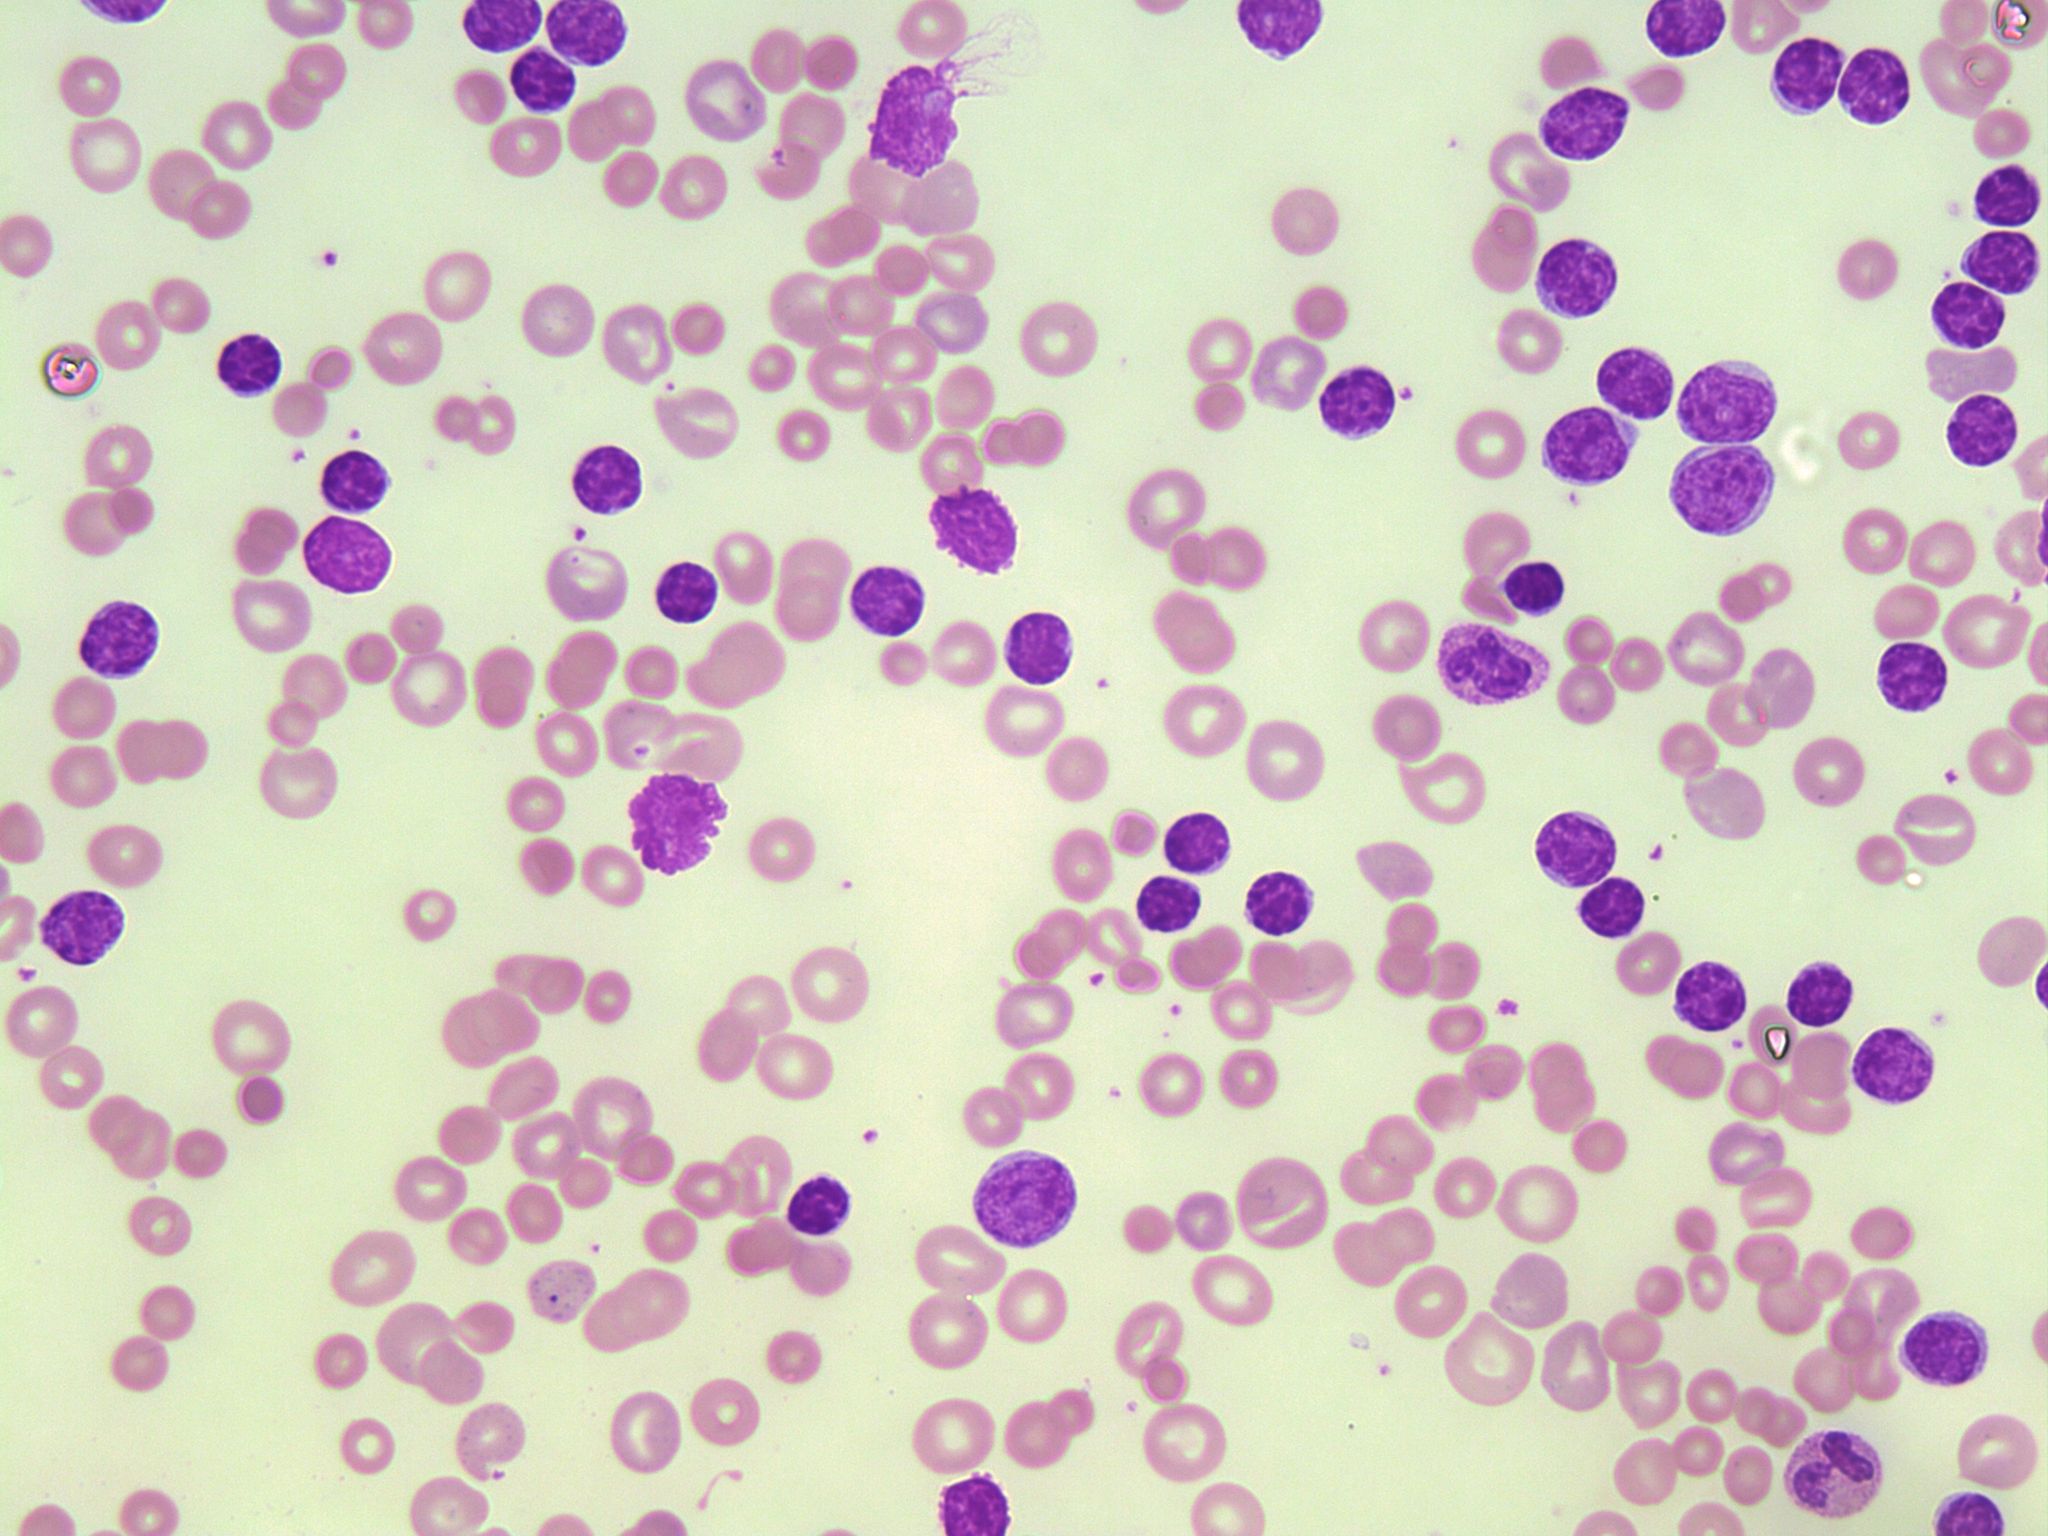

1. ¿Qué es la leucemia linfocítica crónica?
La leucemia linfocítica crónica (LLC) es una enfermedad sutil pero progresiva que afecta principalmente a los linfocitos, un tipo de glóbulo blanco esencial en el sistema inmunológico. Este trastorno sanguíneo se caracteriza por la acumulación gradual de linfocitos B maduros, los cuales son resistentes a la muerte celular y se replican de manera anómala. Con el tiempo, estos linfocitos alterados pueden desplazar a las células sanguíneas normales, conduciendo a síntomas como fatiga, riesgo incrementado de infecciones y anemia.
Considerada la forma más común de leucemia en adultos, especialmente en aquellos mayores de 60 años, la LLC se diagnostica normalmente durante exámenes de rutina, dado que en su etapa inicial puede no manifestar síntomas claros. Se trata de una condición con un amplio espectro de comportamiento; algunos pacientes pueden vivir durante muchos años sin tratamiento, mientras que otros podrían necesitar intervenciones terapéuticas para controlar la enfermedad.
En comparación con otros tipos de leucemia, la LLC tiene una peculiaridad: en la mayoría de los casos su avance es lento, lo que permite a los médicos y pacientes monitorear la enfermedad cuidadosamente antes de tomar decisiones críticas en cuanto al tratamiento. Aunque no tiene cura conocida, su manejo incluye una variedad de opciones que pueden prolongar la supervivencia y mejorar la calidad de vida de los afectados. Esta enfermedad también presenta un factor hereditario, lo que significa que quienes tienen familiares con LLC podrían tener mayor riesgo de desarrollarla.
2. Síntomas de la leucemia linfocítica crónica
Fatiga y debilidad: Muchos pacientes experimentan una fatiga persistente y una sensación general de debilidad, lo cual puede incidir significativamente en la calidad de vida. Estos síntomas resultan de la anemia que se desarrolla debido a la insuficiencia de la médula ósea para producir suficientes glóbulos rojos sanos.
Infecciones recurrentes: Dada la alteración del sistema inmunológico, las personas con leucemia linfocítica crónica pueden sufrir infecciones con más frecuencia, incluyendo las respiratorias. Esto se debe a la disminución de la función inmunitaria normal ya que las células leucémicas no combaten infecciones efectivamente como las células linfáticas sanas.
Adenomegalias: Uno de los signos más evidentes es el crecimiento indoloro de los ganglios linfáticos, especialmente en áreas como el cuello, las axilas o la ingle. La acumulación de linfocitos leucémicos en los ganglios linfáticos provoca este abultamiento característico.
Sensación de saciedad y dolor abdominal: La esplenomegalia, o agrandamiento del bazo, es otro síntoma común. Esto puede conducir a una sensación de plenitud incluso después de comer pequeñas cantidades de alimentos y a veces resulta en dolor abdominal debido a la presión en el área circundante.
Pérdida de peso sin razón aparente: Aunque no es específica de la leucemia linfocítica crónica, la pérdida de peso involuntaria es un síntoma de alerta que a menudo se observa en trastornos hematológicos avanzados y puede ser un indicio de una enfermedad sistémica.
3. Factores de riesgo para la leucemia linfocítica crónica
La incidencia de la leucemia linfocítica crónica (LLC) aumenta con la edad, siendo más común en adultos mayores de 60 años. Además, las personas que tienen un familiar directo con LLC tienen un riesgo mayor de desarrollar la enfermedad. Estudios han mostrado que la predisposición genética juega un papel importante en la aparición de la LLC. Aunque no es una condición exclusivamente hereditaria, la presencia del trastorno en la historia familiar es un factor de riesgo a considerar para un diagnóstico temprano y seguimiento adecuado.

La LLC tiene una prevalencia más alta en hombres que en mujeres, y aunque la causa exacta no está clara, se sugiere que las diferencias hormonales pueden influir en su desarrollo. Por otra parte, la exposición a ciertos químicos, como los pesticidas y solventes, se ha asociado con un incremento en el riesgo de desarrollar diversos tipos de leucemia, incluida la LLC. También es relevante considerar que los trabajadores de la agricultura y aquellos empleados en la industria química podrían estar más expuestos a estas sustancias nocivas. En ese contexto, se recomienda la adopción de medidas de protección y prevención en entornos laborales y personales para minimizar la exposición a agentes químicos potencialmente peligrosos.

Ciertos estilos de vida podrían tener una influencia en el riesgo de desarrollar leucemia linfocítica crónica. Por ejemplo, el tabaquismo es conocido por su capacidad de dañar el ADN de las células, incluidas las células del sistema inmunológico, lo que puede conducir a mutaciones y al desarrollo de cánceres como la LLC. Por otro lado, estudios han sugirido que un sistema inmunológico comprometido puede también incrementar el riesgo de enfermedades hematológicas malignas. Esto incluye a individuos con enfermedades autoinmunes o aquellos que han recibido trasplantes de órganos. Entender estos factores de riesgo permite a los profesionales de la salud y a los pacientes tomar decisiones informadas sobre su salud y adoptar hábitos que podrían disminuir la posibilidad de desarrollar LLC.

4. Principales alteraciones genéticas en la leucemia linfocítica crónica
Mutaciones del gen TP53
Una de las alteraciones genéticas más comunes y con mayor impacto en la leucemia linfocítica crónica (LLC) es la mutación del gen TP53. Este gen es crucial pues codifica una proteína que suprime la formación de tumores, controlando el ciclo celular y promoviendo la apoptosis. Cuando TP53 está mutado, las células cancerosas pueden proliferar sin control, lo que conduce a un pronóstico más desfavorable para los pacientes.

Deleciones del cromosoma 13q
Las deleciones en el brazo largo del cromosoma 13 (13q) representan otro cambio genético importante en la LLC. Esta alteración es a menudo un indicador de un curso menos agresivo del cáncer. Sin embargo, el grado y el tamaño de la deleción pueden afectar considerablemente el pronóstico del paciente. Las deleciones en 13q pueden llevar a una pérdida de genes reguladores claves, impactando las vías celulares involucradas en la regulación de la apoptosis y la proliferación celular.

Alteraciones en IGHV
El estado de mutación de la región variable del gen de inmunoglobulina pesada (IGHV) también es determinante para la progresión de la LLC. Los pacientes con IGHV no mutado tienden a tener un pronóstico menos favorable en comparación con aquellos que tienen IGHV mutado. Estas diferencias en el estado de mutación de IGHV pueden influir en la agresividad del cáncer y en la respuesta al tratamiento.
5. Estudios de laboratorio en la leucemia linfocítica crónica
Citometría de flujo
La citometría de flujo es una tecnología crucial en el diagnóstico y seguimiento de la leucemia linfocítica crónica (LLC). Esta técnica permite la detección de células anormales en sangre, caracterizándolas por su tamaño, granulosidad y la presencia de marcadores específicos en su superficie. Es especialmente útil para evaluar la expresión de CD5 y CD23, marcadores habitualmente encontrados en las células B malignas de la LLC.
Análisis genético
Las alteraciones genéticas son comunes en la LLC y tienen implicaciones en el pronóstico y la terapia. El análisis genético puede identificar mutaciones en genes como TP53 o IGHV que están asociadas con una evolución más agresiva de la enfermedad. Técnicas como FISH (hibridación fluorescente in situ) o secuenciación de nueva generación ofrecen una vista detallada del perfil genético del paciente y ayudan a personalizar el tratamiento.
Perfil hematológico completo
El perfil hematológico completo es un pilar en la evaluación inicial y el seguimiento de los pacientes con LLC. La medición de la cuenta leucocitaria, la fórmula leucocitaria y la evaluación de anemia o trombocitopenia son indispensables. Estos parámetros pueden reflejar la progresión de la enfermedad y la respuesta al tratamiento, así como detectar posibles complicaciones de la terapia.
Estudio de inmunoglobulinas
Con la finalidad de entender mejor el funcionamiento del sistema inmune del paciente con LLC, se estudian los niveles de inmunoglobulinas. Estos estudios pueden revelar hipogammaglobulinemia, un estado característico en pacientes con LLC que aumenta el riesgo de infecciones. La monitorización de los niveles de inmunoglobulinas puede influir en la decisión de administrar terapias de reemplazo o profilaxis antimicrobiana.
6. Ayuda para pacientes con leucemia linfocítica crónica en México
Entender el diagnóstico de leucemia linfocítica crónica puede ser un momento abrumador para muchos pacientes y sus familias. Sin embargo, no están solos en esta lucha. En México, existen diversas organizaciones y programas dedicados a brindar apoyo médico, emocional y de información estratégica que ayudan en el camino hacia el tratamiento y la mejora de la calidad de vida.
Estos grupos de ayuda proporcionan acceso a tratamientos innovadores, terapias y ensayos clínicos específicos para este tipo de leucemia. Además, se organizan eventos y reuniones que buscan no solo informar, sino también crear una comunidad donde los pacientes pueden compartir experiencias y consejos útiles para el manejo de la enfermedad en el día a día.
Las principales ciudades como México DF y Guadalajara se destacan por contener centros de asistencia con personal altamente capacitado. Ofrecen servicios de valor inestimable, incluyendo asesoramiento genético, estudios de laboratorio especializados y acceso a nuevas tecnologías en el campo de la hematología.
7. Ayuda a pacientes con leucemia linfocítica crónica en Guadalajara
En la lucha contra la leucemia linfocítica crónica, cada acción cuenta, especialmente en la hermosa ciudad de Guadalajara, donde la solidaridad se refleja en cada rincón. Nos comprometemos a ofrecer apoyo integral para quienes enfrentan este desafío, no solo en el aspecto médico, sino también en el emocional, brindando un rayo de esperanza a través de la comunidad y la comprensión.
Entendemos que el camino es difícil, pero no imposible. Por eso, nuestra red de apoyo está equipada con profesionales dedicados, ofreciendo desde asesoría hasta terapias complementarias y grupos de apoyo. Creemos firmemente que, con la unión de esfuerzos, pacientes y familiares encontrarán la fortaleza para superar cada obstáculo en esta jornada. Juntos, podemos hacer de Guadalajara un modelo de apoyo y resistencia frente a la adversidad.
8. ¿Cómo se diagnostica la leucemia linfocítica crónica?
El primer paso para el diagnóstico de la leucemia linfocítica crónica (LLC) usualmente comienza cuando un paciente presenta síntomas inespecíficos que lo llevan a consultar a su médico. La manifestación clínica inicial puede incluir fatiga persistente, inflamación indolora de los ganglios linfáticos, fiebre sin causa aparente y sudoración nocturna. Es importante destacar que algunos pacientes pueden ser asintomáticos y su diagnóstico se realiza a partir de hallazgos incidentales en estudios sanguíneos de rutina.
Una vez que se plantea la posibilidad de LLC, el diagnóstico se confirma con análisis de laboratorio enfocados. Esto incluye un hemograma completo que suele revelar un recuento elevado de linfocitos, anemia y trombocitopenia. Posteriores estudios de inmunofenotipado a través de citometría de flujo permiten identificar las células B típicas de la LLC por medio de sus marcadores característicos CD5, CD19, CD20 y CD23. La citogenética y la FISH (hibridación fluorescente in situ) son pruebas genéticas que ayudan a identificar alteraciones cromosómicas asociadas con pronósticos específicos dentro de esta enfermedad. La calidad de las imágenes debe incentivar la comprensión y el apoyo a los pacientes durante el proceso diagnóstico.
Los centros de ayuda para pacientes con LLC en México y Guadalajara proveen apoyo durante el proceso de diagnóstico y tratamiento. La comprensión del procedimiento y la aclaración de dudas puede representar un gran alivio para el paciente y sus familiares en este difícil momento.

El diagnóstico de la LLC conlleva un impacto emocional significativo para los pacientes y sus seres queridos. En México y Guadalajara existen grupos de apoyo y organizaciones que ofrecen asesoramiento, información sobre la enfermedad y orientación respecto a los recursos disponibles. Estas asociaciones colaboran estrechamente con los equipos sanitarios para facilitar un abordaje integral de la enfermedad, que incluye el cuidado psicológico y emocional, además del tratamiento médico.

9. Tratamientos disponibles para la leucemia linfocítica crónica
La lucha contra la leucemia linfocítica crónica (LLC) ha avanzado considerablemente en los últimos años, ofreciendo esperanza a aquellos que enfrentan esta enfermedad. Los esfuerzos médicos se han enfocado en desarrollar terapias que no solo prolonguen la vida sino que también mejoren su calidad. Estos son algunos de los tratamientos más efectivos disponibles a la fecha:
Terapias dirigidas: Estos tratamientos modernos apuntan a componentes específicos de las células cancerosas. Por ejemplo, los inhibidores de tirosina quinasa (TKI) que bloquean las señales que promueven la supervivencia del cáncer, mejorando así el pronóstico y reduciendo los efectos adversos. Son un componente clave en las terapias personalizadas de la LLC.
Quimioterapia: A pesar de la aparición de nuevas terapias, la quimioterapia sigue siendo un pilar en el tratamiento de la LLC. Mediante la combinación de varios fármacos citotóxicos, se busca eliminar las células cancerígenas. La selección y combinación de estos fármacos dependerá de la etapa de la enfermedad y de la condición general del paciente.
Inmunoterapia: Esta forma de tratamiento reactiva el sistema inmunitario para que reconozca y destruya las células cancerosas. Por ejemplo, los anticuerpos monoclonales se enlazan específicamente a las células de la LLC, marcándolas para su destrucción por parte del sistema inmune.
Trasplante de células madre: Aunque se reserva para casos selectos debido a su naturaleza invasiva y los riesgos asociados, el trasplante de células madre puede ofrecer la posibilidad de una cura, reemplazando las células enfermas por células sanas y regenerativas de un donante compatible.
Además de estos tratamientos, se están investigando numerosas terapias innovadoras en ensayos clínicos, buscando siempre el mejor resultado para el paciente. Cada caso de LLC es único, y por ello, el enfoque terapéutico debe ser personalizado y considerar tanto las características de la enfermedad como las del paciente. La elección del tratamiento adecuado es una decisión compleja que debe ser tomada por un equipo de especialistas en oncología, quienes tendrán en cuenta las más recientes investigaciones y guías clínicas.
10. Terapia dirigida en la leucemia linfocítica crónica
Agentes monoclonales
Los agentes monoclonales son uno de los pilares de la terapia dirigida que revolucionaron el tratamiento de la leucemia linfocítica crónica (LLC). Estos medicamentos, como el rituximab, buscan proteínas específicas en la superficie de las células cancerosas, marcándolas para que sean destruidas por el sistema inmune. Su eficacia y menor incidencia de efectos secundarios comparados con la quimioterapia les han hecho fundamentales en el manejo actual de la enfermedad.
Inhibidores de tirosina quinasa
Los inhibidores de tirosina quinasa, como ibrutinib, atacan las células cancerosas interfiriendo con las señales químicas que les indican que se multipliquen y sobrevivan. Estos fármacos han mostrado una gran efectividad en pacientes con LLC que no han respondido a otros tratamientos, ofreciendo una opción valiosa para aquellos con enfermedad recurrente o refractaria.
Fármacos BCL-2
Los fármacos que inhiben la proteína BCL-2, como venetoclax, representan otro enfoque de la terapia dirigida. La proteína BCL-2 ayuda a las células cancerosas a evitar la muerte celular programada o apoptosis. Inhibiéndola, venetoclax restablece el proceso de apoptosis en las células de leucemia, llevando a su eliminación. Este tratamiento se ha convertido en una herramienta poderosa, especialmente en pacientes que han desarrollado resistencia a otros tratamientos dirigidos.
11. Quimioterapia en el tratamiento de la leucemia linfocítica crónica
La quimioterapia sigue siendo una piedra angular en el tratamiento de la leucemia linfocítica crónica (LLC), una enfermedad que afecta predominantemente a adultos mayores y que se caracteriza por la acumulación de linfocitos B malignos en la sangre, la médula ósea y los órganos linfoides. Aunque la aparición de terapias dirigidas ha revolucionado el enfoque terapéutico, la quimioterapia mantiene un papel vital por su eficacia y accesibilidad, especialmente en contextos donde el acceso a tratamientos de nueva generación puede ser limitado.
En los regímenes de quimioterapia, se utilizan combinaciones de fármacos que atacan las células cancerígenas de manera sinérgica, buscando reducir su número y controlar la progresión de la enfermedad. Los protocolos de tratamiento son personalizados, dependiendo de múltiples factores clínicos y genéticos que influyen en la respuesta terapéutica del paciente. A continuación, detallaremos algunos de los esquemas quimioterapéuticos más empleados y sus respectivas características:
FRC (Fludarabina, Ciclofosfamida y Rituximab): Esta combinación es una de las más utilizadas. La fludarabina es un análogo de nucleósido que inhibe la síntesis de ADN, la ciclofosfamida es un agente alquilante que forma enlaces cruzados en el ADN, y el rituximab es un anticuerpo monoclonal que se dirige a la proteína CD20 positiva en las células B malignas.
Clorambucil con o sin prednisona: El clorambucil, un agente alquilante tradicionalmente usado en pacientes de mayor edad o con comorbilidades, puede ser prescrito solo o en combinación con prednisona para mitigar algunos de los efectos secundarios y mejorar la respuesta inmune.
Bendamustina: Otro agente alquilante que ha mostrado ser efectivo en monoterapia o en combinación con rituximab, y se ha convertido en una opción destacada por su perfil de toxicidad favorable y eficacia en pacientes que no han respondido adecuadamente a otras terapias.
Regímenes sin quimioterapia (terapia dirigida): Con el avance científico, han surgido tratamientos que focalizan específicamente en dianas moleculares relacionadas con la proliferación de las células malignas, como inhibidores de la tirosina quinasa BTK, que son especialmente útiles en pacientes con contraindicaciones para la quimioterapia.
La elección de un esquema de quimioterapia debe ser una decisión individualizada, basada en una evaluación integral de la enfermedad y el perfil de cada paciente. Con el apoyo de un equipo multidisciplinario y una infraestructura hospitalaria adecuada, los pacientes pueden recibir el tratamiento más apropiado y manejar de manera efectiva los efectos secundarios asociados con la quimioterapia.
12. Trasplante de médula ósea en la leucemia linfocítica crónica
¿Qué es el trasplante de médula ósea?
El trasplante de médula ósea es un procedimiento médico que reemplaza la médula ósea enferma o dañada con células madre saludables. Este procedimiento puede ser una opción de tratamiento para pacientes con leucemia linfocítica crónica cuando otras terapias no han funcionado. La médula ósea es el tejido esponjoso dentro de los huesos que produce las células sanguíneas vitales para nuestro cuerpo.
Elegibilidad para el trasplante
Para determinar si un paciente es candidato para un trasplante de médula ósea, se realizan análisis detallados de hematología. El estado general de salud, la etapa de la leucemia y la presencia de comorbilidades son factores críticos. La compatibilidad genética con un donante es también esencial para aumentar las probabilidades de éxito y minimizar los riesgos de rechazo.
El proceso del trasplante
El proceso del trasplante puede ser largo y requiere una hospitalización que puede extenderse durante varias semanas. Después de la extracción de las células madre del donante, el paciente pasa por un periodo de condicionamiento, donde la médula ósea existente se destruye mediante quimioterapia y/o radioterapia antes del trasplante. Luego, las células madre se infunden en el paciente, donde se espera que comiencen a generar nuevas células sanguíneas saludables.
Cuidados post-transplante
Tras el trasplante, el paciente debe permanecer en un ambiente controlado para evitar infecciones mientras su sistema inmunológico se recupera. Se requiere un seguimiento médico constante para monitorear la recuperación y detectar tempranamente cualquier signo de complicación, como el rechazo del injerto o la enfermedad injerto contra huésped, donde las células del donante atacan al cuerpo del paciente.
13. Ensayos clínicos en la leucemia linfocítica crónica
Los ensayos clínicos desempeñan un papel fundamental en el avance del tratamiento y manejo de la leucemia linfocítica crónica (LLC). A través de estos estudios, investigadores y médicos buscan nuevas formas de mejorar el pronóstico y la calidad de vida de los pacientes. Los ensayos clínicos no solo abren el camino hacia tratamientos innovadores, sino que también ofrecen a los pacientes la oportunidad de acceder a terapias de vanguardia antes de que estén ampliamente disponibles.
Identificación de nuevos fármacos: Continuamente se está en la búsqueda de compuestos con el potencial de superar la efectividad de los tratamientos convencionales. Los ensayos clínicos evalúan la seguridad y eficacia de estas nuevas sustancias en distintas etapas de desarrollo.
Optimización de combinaciones terapéuticas: Los estudios también están enfocados en encontrar la combinación más efectiva de tratamientos ya existentes, para potenciar su efectividad y disminuir posibles efectos secundarios.
Desarrollo de terapias dirigidas: Una promisoria área de estudio son las terapias que se enfocan en blancos moleculares específicos de las células cancerosas, con el objetivo de eliminarlas con mayor precisión y menos daño a tejidos sanos.
Avances en inmunoterapia: Otra línea de investigación relevante es la que explora la capacidad del propio sistema inmunológico para combatir el cáncer, personalizando el tratamiento según las características individuales de cada paciente.
Mejora de estrategias de seguimiento y mantenimiento: Hay ensayos dirigidos a estandarizar y optimizar las pautas de seguimiento, con el fin de detectar precozmente recaídas y ajustar los tratamientos de mantenimiento para prolongar la remisión de la enfermedad.
Participar en un ensayo clínico puede ser una decisión significativa para los pacientes. Se les recomienda discutir las opciones con su equipo de cuidado de la salud, considerando tanto los beneficios potenciales como los riesgos involucrados. En México, instituciones como el Instituto Nacional de Cancerología (INCan) lideran estos estudios esperanzadores, brindando nuevas alternativas para aquellos afectados por la LLC.
14. Cuidados paliativos en la leucemia linfocítica crónica
Los cuidados paliativos en la leucemia linfocítica crónica (LLC) son esenciales para mejorar la calidad de vida de los pacientes enfrentando esta condición. Estos cuidados se centran en aliviar los síntomas y el dolor, además de ofrecer soporte emocional y psicológico tanto para el paciente como para su familia. Es importante entender que los cuidados paliativos se pueden implementar en cualquier etapa de la enfermedad y no se limitan al final de la vida.
La personalización del tratamiento paliativo es vital, tomando en cuenta las necesidades únicas de cada individuo. Los especialistas en cuidados paliativos trabajan en equipo para diseñar un plan que puede incluir medicación para el dolor, terapia nutricional, y técnicas de relajación, entre otros métodos de soporte.

El manejo del dolor es un componente crítico de los cuidados paliativos para pacientes con leucemia linfocítica crónica. Los especialistas pueden emplear analgésicos, como opioides, para controlar el dolor moderado a severo. Sin embargo, es crucial monitorear y ajustar estas medicaciones para evitar efectos secundarios y mantener la calidad de vida.
Además, los síntomas como fatiga, pérdida de apetito y dificultades para dormir son comúnmente tratados a través de intervenciones multidisciplinarias. Esto puede incluir programas de ejercicio adaptados, asesoría nutricional, y terapias de sueño. Estas intervenciones están diseñadas para preservar la energía y mejorar el bienestar general del paciente.

El soporte emocional desempeña un rol crucial en los cuidados paliativos para quienes padecen de leucemia linfocítica crónica. Los pacientes pueden experimentar estrés, depresión y ansiedad debido a la naturaleza crónica y progresiva de la enfermedad. La intervención de psicólogos y trabajadores sociales ayuda a abordar estos problemas emocionales.
Los familiares también reciben apoyo para manejar la carga emocional y logística que acompaña al cuidado de un ser querido con una condición crónica. Grupos de apoyo, terapia familiar y servicios de consejería pueden proporcionar un espacio seguro para expresar sentimientos y aprender estrategias de afrontamiento.

15. Consejos para pacientes con leucemia linfocítica crónica
El diagnóstico de leucemia linfocítica crónica puede ser un momento difícil y de incertidumbre, pero es importante recordar que no está solo. Hay medidas que puede tomar para manejar su condición y mantener la mejor calidad de vida posible. Una de las primeras recomendaciones es educarse sobre su enfermedad. Entender sus particularidades y los posibles tratamientos le dará un sentido de control y le permitirá tomar decisiones informadas sobre su cuidado médico.
Es fundamental llevar una vida saludable, con una dieta bien balanceada rica en frutas, verduras y granos integrales. La actividad física también es importante; hable con su médico sobre qué tipo de ejercicio es apropiado para usted. Mantenerse activo puede ayudar a reducir la fatiga, uno de los síntomas comunes de la leucemia linfocítica crónica. Además, es crucial descansar lo suficiente y manejar el estrés eficientemente. Técnicas como la meditación o la terapia cognitivo-conductual pueden ser herramientas útiles.
La comprensión y apoyo de amigos y familiares es invaluable. Considere unirse a un grupo de apoyo, ya sea presencial o en línea, para conectarse con otras personas que estén pasando por situaciones similares. Compartir experiencias y consejos puede ser extremadamente beneficioso. Hay asociaciones y organizaciones que ofrecen ayuda a pacientes con leucemia en ciudades como México y Guadalajara, proporcionando desde asesoramiento sobre tratamientos hasta apoyo emocional.
Finalmente, el cuidado clínico regular es vital. Mantenga comunicación constante con su equipo médico y no dude en hacer preguntas o compartir sus preocupaciones. Los avances en la medicina ofrecen cada vez más opciones para el tratamiento y manejo de la leucemia linfocítica crónica, por lo que es importante estar al tanto de los últimos desarrollos y discutir la posibilidad de participación en ensayos clínicos o nuevas terapias.
Recuerde, cada paso que tome es importante para su salud y bienestar. Con el tratamiento correcto y un enfoque proactivo para el cuidado de su salud, puede vivir una vida plena y activa, incluso con leucemia linfocítica crónica.
16. Recursos y apoyo para pacientes con leucemia linfocítica crónica
Asociaciones de apoyo
Las asociaciones dedicadas al soporte de pacientes con leucemia linfocítica crónica juegan un papel vital en proporcionar recursos emocionales y prácticos. Ofrecen desde grupos de apoyo hasta información actualizada sobre los tratamientos más efectivos. Su misión es asegurarse de que los pacientes y sus familias no se enfrenten solos a esta enfermedad.
En México, organizaciones como la Asociación Mexicana de Leucemias y Linfomas (AMELYL) tienen el compromiso de brindar ayuda integral, incluyendo orientación psicológica y asesoramiento legal en aspectos relacionados con el cuidado de la salud.
Centros especializados
Los centros especializados en hematología ofrecen un enfoque completo en el diagnóstico y tratamiento de la leucemia linfocítica crónica. Estos centros utilizan equipos de alta tecnología y profesionales altamente calificados para asegurar que el paciente reciba un cuidado acorde a las últimas innovaciones en la medicina.
En Guadalajara, instituciones como el Instituto Jalisciense de Cancerología están equipados con la infraestructura requerida para realizar estudios de laboratorio avanzados como la citometría de flujo, permitiendo una caracterización detallada de la enfermedad para una terapia personalizada.
Programas educativos
La educación es un recurso esencial. Muchas asociaciones y centros médicos ofrecen programas educativos para pacientes y sus familias, donde se explican aspectos clave de la leucemia linfocítica crónica, desde las alteraciones genéticas más comunes como la deleción 17p hasta la importancia de la citometría de flujo en la estratificación del riesgo.
Estos programas no solo buscan informar, sino también empoderar a los pacientes para que tomen decisiones informadas sobre su tratamiento y manejo de la enfermedad, aún ante escenarios cambiantes y a veces desafiantes.
17. Investigaciones y avances en el tratamiento de la leucemia linfocítica crónica

Desarrollo de terapias dirigidas
La medicina moderna ha logrado grandes avances en la comprensión y el tratamiento de la leucemia linfocítica crónica (LLC). Con el desarrollo de terapias dirigidas, los investigadores han podido enfocar el tratamiento hacia las células cancerígenas con mayor precisión, minimizando los efectos sobre las células sanas. Estas terapias se han convertido en parte fundamental del arsenal de tratamiento contra la LLC, ofreciendo esperanza para una mayor supervivencia y calidad de vida en los pacientes.

Ensayos clínicos innovadores
Los ensayos clínicos constituyen un pilar clave en la lucha contra la leucemia linfocítica crónica. Gracias a estos estudios controlados, especialistas de todo el mundo evalúan la eficacia de nuevos fármacos y combinaciones de tratamiento. La participación de pacientes voluntarios es imprescindible para el avance de la ciencia y el desarrollo de estos medicamentos que buscan no solo alargar la supervivencia, sino también mejorar la calidad de vida de los pacientes afectados por esta enfermedad.

Revolución genómica
El estudio detallado del genoma humano ha traído una revolución en el tratamiento de la leucemia linfocítica crónica. La identificación de alteraciones genéticas específicas en cada paciente permite adaptar los tratamientos a su perfil único, una práctica conocida como medicina de precisión. Este enfoque personalizado ha mejorado significativamente los resultados, permitiendo terapias más efectivas y con menos efectos secundarios indeseados.
18. Prevención de la leucemia linfocítica crónica
Si bien la leucemia linfocítica crónica (LLC) es una enfermedad con una etiología en gran medida desconocida y no se considera ampliamente prevenible, ciertos estilos de vida y medidas pueden contribuir a reducir el riesgo general de desarrollar cánceres, incluida la LLC. La información a continuación recorre algunas estrategias de prevención general que, si bien no garantizan la eliminación del riesgo, podrían ser de gran ayuda en la vida cotidiana.
Mantener un estilo de vida saludable: Aunque no existe una forma segura de prevenir la leucemia linfocítica crónica, llevar una vida activa con una dieta equilibrada rica en frutas y verduras puede ayudar a fortalecer el sistema inmunitario y reducir el riesgo de cáncer en general.
Evitar la exposición a químicos peligrosos: Algunos estudios sugieren que la exposición a ciertos pesticidas y herbicidas podría estar asociada con un riesgo aumentado de LLC. Es fundamental usar protección adecuada al manejar estas sustancias y seguir las pautas de seguridad pertinentes.
Realizar chequeos médicos regulares: Aunque los exámenes de detección a menudo no se utilizan para la leucemia debido a la naturaleza de la enfermedad, estar al tanto de la propia salud con chequeos periódicos puede llevar a una detección más temprana y mejorar el pronóstico de la enfermedad.
Evitar el tabaco: Fumar no solo está vinculado al cáncer de pulmón y otros trastornos, sino que también puede aumentar el riesgo de leucemia. Es fundamental dejar de fumar para reducir dicho riesgo.
Es importante notar que, aunque estas acciones pueden contribuir a una mejor salud general, su efectividad específica en la prevención de la leucemia linfocítica crónica es incierta. Sin embargo, adoptar estas prácticas beneficia el bienestar integral del individuo y puede tener efectos positivos en la prevención de otras enfermedades.
19. Estadísticas sobre la leucemia linfocítica crónica
20M
Casos globales
Estimados de pacientes afectados por leucemia linfocítica crónica a nivel mundial.
EK
Nuevos casos México
Cantidad de nuevos diagnósticos reportados anualmente en México.
82%
Tasa de supervivencia
Porcentaje de pacientes que sobreviven 5 años después del diagnóstico.
65
Edad promedio
Edad media al momento del diagnóstico de la enfermedad.
La leucemia linfocítica crónica (LLC) representa un desafío para la salud mundial, siendo una de las formas más comunes de leucemia en adultos. A nivel global, los datos indican que hay aproximadamente 20 millones de casos existentes, reflejando tanto diagnosticados como proyecciones epidemiológicas. Esta estadística pone de relieve la magnitud de la enfermedad y la necesidad de investigación continua para encontrar tratamientos más efectivos.
De manera particular, en México se reportan cerca de 5,000 nuevos casos anuales, una cifra que resalta la importancia de programas de concienciación y detección temprana. Con una atención especializada y un diagnóstico oportuno, los pacientes pueden acceder a terapias que mejoran significativamente su pronóstico.
Uno de los indicadores más esperanzadores es la tasa de supervivencia. Gracias a los avances en los tratamientos, el 82% de los pacientes logran sobrevivir más de 5 años después de ser diagnosticados. Este dato subraya el progreso alcanzado en la lucha contra la LLC y justifica el optimismo cauteloso de la comunidad médica y los pacientes.
La edad promedio al diagnóstico es de 65 años, lo que sugiere que es una enfermedad que afecta principalmente a las personas de edad avanzada. Aun así, es crucial no descartar síntomas en poblaciones más jóvenes, ya que la detección temprana es clave para un tratamiento exitoso.
20. Comunidad y foros de apoyo para pacientes con leucemia linfocítica crónica
Enfrentar la leucemia linfocítica crónica es un camino que nadie debería recorrer solo. Con el objetivo de proveer un espacio seguro y empático, hemos creado una comunidad donde los pacientes, familiares y amigos pueden compartir experiencias, obtener información y encontrar apoyo emocional. Los foros de discusión facilitan la conexión con otras personas que comprenden por lo que estás pasando y pueden ofrecer consejos basados en sus propias experiencias.
Nuestra comunidad en línea está repleta de historias inspiradoras, consejos prácticos y recursos útiles. Aquí encontrarás desde información actualizada sobre los últimos tratamientos hasta maneras de lidiar con los desafíos cotidianos que presenta esta enfermedad. También organizamos eventos periódicamente en México y Guadalajara, donde puedes conocer a otros miembros de la comunidad y fortalecer lazos en un ambiente amistoso y acogedor.
Te invitamos a unirte a nosotros y descubrir que la esperanza y el apoyo están más cerca de lo que piensas. Haz clic en los botones a continuación para registrarte en nuestra comunidad o para obtener más información sobre el apoyo disponible para los pacientes con leucemia linfocítica crónica y sus seres queridos.
21. Historias de éxito de pacientes con leucemia linfocítica crónica
La batalla contra la leucemia linfocítica crónica (LLC) es ardua y desafiante. Sin embargo, hay relatos llenos de esperanza y fortaleza que sirven de inspiración para quienes aún luchan. Esas historias de éxito reflejan no solo la resistencia del espíritu humano, sino también los avances médicos que han mejorado el pronóstico de esta enfermedad.
Uno de los testimonios más conmovedores proviene de Carlos, un maestro de Guadalajara que fue diagnosticado con LLC a los 52 años. Tras varios ciclos de tratamiento y el apoyo constante de su familia, Carlos logró una remisión completa. Su historia subraya la importancia de un diagnóstico temprano y un tratamiento personalizado. Los momentos más brillantes de su lucha los compartió en grupos de apoyo, convirtiéndose en un faro de optimismo para otros pacientes.
21.1. Superando barreras con la ayuda de la ciencia y la comunidad
Laura, por otro lado, fue una paciente de la Ciudad de México que entendió que el camino hacia la recuperación no se recorrida solo. Al sumarse a una comunidad en línea, se benefició enormemente del intercambio de experiencias. Los avances en terapias dirigidas y la citometría de flujo jugaron un papel esencial en el seguimiento de su enfermedad, permitiéndole a ella y a su equipo médico adaptar la terapia a medida que progresaba la enfermedad.
Estas historias, y muchas otras similares, son testimonio vivo de cómo la investigación continua, la solidaridad y el cuidado personalizado transforman la vida de las personas con LLC. Además de los tratamientos, el apoyo emocional es un pilar clave en la recuperación y la calidad de vida después del diagnóstico.
En México, organizaciones caritativas y hospitales en ciudades como Mérida y Guadalajara ofrecen servicios integrales que incluyen asesoramiento psicológico, asistencia financiera y grupos de apoyo. Estas instituciones están en la vanguardia de proveer una red de apoyo a quienes enfrentan la enfermedad, construyendo comunidades de pacientes, familias y profesionales dedicados a mantener encendida la llama de la esperanza.
22. Contacto y ubicación de centros especializados en leucemia linfocítica crónica
Hospitales de referencia
Para recibir la mejor atención en el tratamiento de la leucemia linfocítica crónica, es indispensable acudir a centros especializados que cuenten con la infraestructura y personal capacitado. En México, ciertas instituciones destacan por su excelencia en hematología y oncología, ofreciendo tratamientos innovadores y atención integral. Localizar un hospital de referencia es un primer paso crucial para encaminar el tratamiento adecuado.
Equipo multidisciplinario
Los equipos de salud multidisciplinarios son fundamentales en la lucha contra la leucemia linfocítica crónica. Se componen de hematologistas, oncólogos, enfermeras especializadas y personal de apoyo que trabajan de manera coordinada para ofrecer una atención personalizada. Los centros especializados disponen de estos profesionales altamente calificados para asegurar un abordaje integral del paciente.
Accesibilidad geográfica
La ubicación geográfica de los centros de tratamiento es un factor determinante para los pacientes y sus familias. Tanto en la Ciudad de México como en Guadalajara existen hospitales accesibles y bien comunicados, permitiendo a los pacientes recibir su tratamiento sin la preocupación adicional del desplazamiento prolongado. Elegir un centro especializado cercano al domicilio puede influir positivamente en la calidad de vida durante el tratamiento.
Apoyo comunitario
El soporte emocional y comunitario es tan crucial como el tratamiento médico en casos de leucemia linfocítica crónica. Existen asociaciones y grupos de apoyo que ofrecen servicios complementarios, como asesoría psicológica, acompañamiento y grupos de ayuda mutua. Estos recursos pueden ser un complemento invaluable en el proceso de sanación y recuperación, además de representar una fuente de fuerza y esperanza para los pacientes y sus seres queridos.
23. Noticias y eventos relacionados con la leucemia linfocítica crónica
Recientemente, un estudio publicado en la prestigiosa revista médica 'Hematología Global' ha revelado hallazgos significativos en la comprensión de las alteraciones genéticas de la leucemia linfocítica crónica (LLC). El equipo de investigación, liderado por la Dra. Elisa Martínez, identificó una correlación entre mutaciones en el gen SF3B1 y una progresión más agresiva de la enfermedad. Este descubrimiento puede conducir a terapias más personalizadas y eficaces para pacientes afectados por esta variante de la leucemia. Otro aspecto destacado del estudio es el potencial uso de la citometría de flujo para detectar y cuantificar células leucémicas con precisión, mejorando así el diagnóstico y seguimiento de la enfermedad. Dada la relevancia de estos descubrimientos, se planea un simposio en la Universidad Nacional de México para discutir las implicaciones clínicas con hematologistas y oncólogos especializados.
En Guadalajara se ha lanzado una campaña de concienciación sobre la leucemia linfocítica crónica, dirigida a promover el entendimiento público de la enfermedad y sus síntomas. La campaña, que comenzó en el mes de marzo, incluye charlas informativas en centros de salud, distribución de folletos educativos y seminarios web gratuitos con expertos en el campo. Además, se ha habilitado una línea telefónica de ayuda para proporcionar apoyo emocional y orientación a los pacientes y sus familias. La organización 'Salud y Esperanza', que patrocina la campaña, también está planificando un evento de recaudación de fondos en el Parque Agua Azul para financiar la investigación y apoyar a los pacientes de LLC con tratamientos no cubiertos por el seguro médico.
La comunidad científica internacional no se queda atrás en la lucha contra la leucemia linfocítica crónica. Este año, se ha establecido una nueva colaboración entre el Instituto de Hematología de México y el Centro de Investigación de Leucemia de Alemania. Esta alianza busca compartir conocimientos y avanzar en la investigación de terapias innovadoras para la LLC. Como parte de esta colaboración, se intercambiarán muestras biológicas y datos clínicos para estudiar en profundidad las alteraciones genéticas de la LLC en diferentes poblaciones. Se espera que esto lleve a una mejor comprensión de la enfermedad a nivel mundial y, eventualmente, a tratamientos más efectivos y personalizados para cada paciente.
24. Recursos adicionales sobre la leucemia linfocítica crónica
La leucemia linfocítica crónica (LLC) puede ser un camino difícil de transitar tanto para los pacientes como para sus seres queridos. Encontrar información confiable y comprensible es crucial para comprender mejor la enfermedad y cómo gestionarla. Existen numerosos recursos adicionales que pueden proveer tanto apoyo emocional como información actualizada acerca de nuevos tratamientos, investigaciones y comunidades de apoyo.
Para los pacientes y familiares en búsqueda de un entendimiento más profundo de la LLC, es esencial explorar una variedad de recursos. Desde publicaciones científicas hasta foros de apoyo, la riqueza de información disponible puede ser abrumadora, pero es importante recordar que no están solos en esta lucha. Organizaciones de pacientes, como grupos locales en México y Guadalajara, suelen organizar eventos informativos y proporcionar materiales educativos especializados en LLC.
Además de los recursos en línea y grupos de apoyo, es posible encontrar talleres y seminarios dados por expertos en el campo. Estas sesiones pueden ser extremadamente útiles para mantenerse al tanto de los últimos avances en terapias y diagnósticos de la LLC. La interacción cara a cara con especialistas proporciona una oportunidad única para que los pacientes hagan preguntas específicas y obtengan respuestas personalizadas a sus inquietudes.
Las bibliotecas y los centros de investigación a menudo disponen de extensas colecciones de material sobre LLC que pueden incluir desde biografías hasta estudios de caso. Sumergirse en estas lecturas no sólo contribuye a una mejor comprensión de la enfermedad, sino que también puede ser una fuente de inspiración y esperanza al leer sobre historias de éxito y superación.


